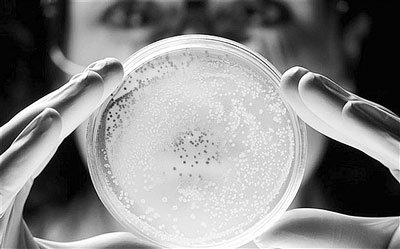

生長在培養皿上的菌落(資料圖)
美國斯坦福大學的科學家和素有“ 科學怪才”之稱的克雷格·文特爾領導的科研小組在《細胞》雜誌 上撰文指出,他們首次利用
電腦 製造出了“虛擬細菌”,其能模擬微生物的生命軌跡和一舉一動。科學家們表示,最新突破或許有助於改進人類對疾病的理解並為疾病找到新的療法。《每日電訊報》在報導中指出,生物學和 電腦 科學的聯姻讓科學家們能藉用電腦腳本模擬生命,這將讓人類大大受益,並有助於回答人類最大也最基本的問題“生命是什麼?”。
“代碼腳本”首次讓生物和電腦“聯姻”
自古以來,當兩種不同的科學思維碰撞在一起時,都會激起人們靈感的火花,讓人類做出更重大的科學突破,分子生物學的誕生就是如此。上世紀50年代中葉,研究遺傳學的生物學家開始同使用X射線研究物質原子結構的物理學家們合作,這場“聯姻”讓人類首次看到了DNA優雅的雙螺旋結構,分子生物學(在分子水平上研究生命現象的科學,主要通過研究核酸、蛋白質等生物大分子的結構、功能和生物合成等方面來闡明各種生命現象的本質,研究內容包括光合作用、癌症的發生等各種生命過程)這門新興學科也在1953年順勢興起,將對人類自身和疾病的研究推到更高的層次。
無獨有偶,另外兩門科學也在慢慢靠近並相互結合。其中一個科學領域是生物學,主要專注於研究DNA指令,正是這些指令決定了活體生物是如何建立起來以及如何運轉的;另一個領域 電腦 科學則專注於研究操作 電腦 運行的代碼。
備受爭議的基因組研究先鋒、美國生物學家克雷格·文特爾目前是讓這兩門科學“聯姻”的積極推手,其實,奧地利的量子力學天才埃爾溫·薛定諤早在1943年提出的“代碼腳本”這一概念正是生物學和 電腦 科學結合的雛形。
薛定諤於1943年發表了一場具有里程碑意義的演講,在那場演講中,薛定諤提出了一個天才性的問題:生命是什麼?薛定諤問道:一個受精卵如何能獲得“一些包含了該生物未來所有發育信息的代碼腳本。”為了回答這個問題,薛定諤提出,染色體就像“非週期性(大分子)晶體”一樣,是一種由同分異構元素連續組成的非週期晶體,構成其的原子具有一個複雜的非重複性的模式;他也描述了該大分子內“原子排列有序的結合”像摩斯代碼中的劃線和點一樣,擁有建立微生物的指令。
這是科學家們首次對遺傳代碼進行嚴肅的討論,儘管與很多同齡人一樣,薛定諤也曾錯誤地認為,遺傳代碼被寫入蛋白質而非核酸中。然而,基於他1943年的演講而撰寫的《生命是什麼》這本書卻給了很多人靈感。其中包括DNA研究領域的開創者、DNA雙螺旋結構的發現者之一吉姆·沃森和文特爾。文特爾在演講中表示:“薛定諤的'代碼腳本'為未來的很多發現指明了方向。”
用 電腦 腳本模擬細菌
現在,文特爾正在撰寫他自己的代碼腳本——使用 電腦 設計基因組。他說:“我們正在嘗試利用 電腦 ,使用遺傳代碼合成出基因組,讓 電腦 科學和生物學完美地聯姻。”
實際上, 電腦 不僅能模擬生命,也能模擬活著的細胞。幾天前,為了幫助人類理解一個細胞的複雜性,斯坦福大學的馬庫斯·卡沃特領導的科研團隊與文特爾的研究機構攜手合作,製造出了虛擬的生殖支原體細菌,並再現了該細菌的整個生命循環過程。該細菌是所有細菌中最簡單的一種,它擁有已知的活體生物中最小的基因組,並且是第二種被排序的非共生微生物。1995年,文特爾對其基因組進行了排序。
生殖支原體細菌目前已經成為首個被詳細建模的微生物,科學家們使用128台 電腦 ,模擬出了其525個基因中每一個基因的詳細情況,也在分子層面繪製出了該細菌從DNA到RNA再到名為代謝物的小分子的情況。
科學家們表示,虛擬細胞和虛擬細菌將幫助他們釐清生命和疾病的本質。當人們談論某個“癌症基因”時,其意思是,他們發現了一個基因,當該基因出故障時,會引發癌症。但是,當人們詳細研究一個癌細胞時就會發現,體內2.3萬個基因中的大部分基因都會受到影響,模擬基因組的整個工作情況,對於理解造成疾病的遺傳原因至關重要。
文特爾表示,用 電腦 來模擬生命、設計生命並“再現生命”,標誌著科學研究將跨入一個新領域,藉此,人類會比以往更接近“生命是什麼”這一終極問題的答案。
留言